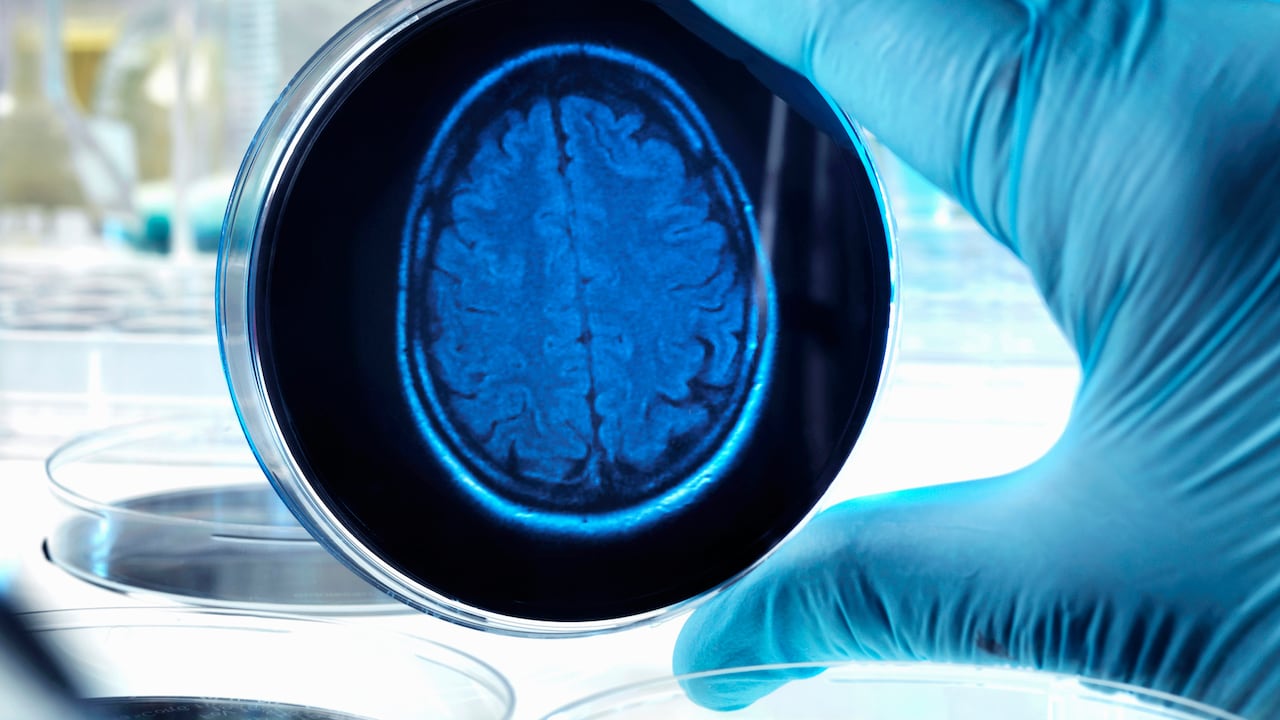
El cerebro también requiere de ciertos cuidados para mantenerse sano.

Varios brotes víricos han hecho que en Australia salten todas las alarmas. Se trata de brotes del virus de la encefalitis japonesa (JEV) en granjas porcinas de Nueva Gales del Sur, Queensland y Victoria, catalogados por el Gobierno australiano como de “importancia nacional”.
Tienen motivos para estar asustados. El virus de la encefalitis japonesa representa la causa más importante de encefalitis viral en el mundo y provoca cerca de 20 000 muertes anuales. Causa daño directo e indirecto al sistema nervioso central, por lo que, de los que sobreviven a la infección, casi la mitad sufre deterioro neurológico irreversible.
Un virus que regresa con fuerza cada diez años
Los estudios genéticos sugieren que el virus de la encefalitis japonesa (JEV) evolucionó originalmente a partir de un flavivirus ancestral, probablemente hace varios milenios, en la región del archipiélago malayo.

Sin embargo, los registros clínicos del virus solo se remontan a principios de la década de 1870, cuando fueron descritos en Japón brotes regulares de encefalitis en verano, con incidentes sustanciales que ocurrían periódicamente a un ritmo aproximado de una vez cada 10 años.

El primer gran brote de la enfermedad se remonta a 1904 y fue denominado “frío de Yoshiwara” o “resfriado de Yoshiwara”. Le siguieron epidemias de encefalitis en 1924, 1935 y 1948. El brote de 1924 causó más de 6 000 casos y 3 000 muertes en 6 semanas. Más recientemente, en el año 2005, se produjeron grandes brotes de encefalitis japonesa en el norte de India y Nepal que ocasionaron 5.000 casos y 1.300 muertes.
Cuatro mil millones de personas en riesgo de infección
Desde que fue descubierto, el virus de la encefalitis japonesa se ha extendido considerablemente y ahora es endémico en la mayor parte de Asia, poniendo a casi 4 000 millones de personas en un riesgo tangible de infección. La enfermedad es endémica en 24 países del sur y sureste de Asia, desde Pakistán hasta Japón, el norte de Australia y Oceanía, lo que supone que prácticamente la mitad de la población mundial está en riesgo de infección.
La incidencia anual de la encefalitis japonesa se estima en alrededor de 69 000 casos, aunque es muy probable que la cifra esté subestimada por la falta de herramientas de diagnóstico precisas. Afecta fundamentalmente a niños. Algunos datos apuntan que el impacto de la enfermedad puede llegar a ser mayor que el del dengue.

Para colmo de males, y a pesar de que los brotes en el hemisferio occidental siguen siendo poco comunes, la situación podría cambiar pronto. La rápida globalización y el cambio climático están facilitando, respectivamente, los viajes internacionales y expandiendo los hábitats de los mosquitos vectores del virus de la encefalitis japonesa. Eso aumenta la probabilidad de que surja la enfermedad en regiones geográficas que anteriormente no estaban afectadas por el virus.
Transmitida por mosquitos de los arrozales
El virus que causa la enfermedad es un arbovirus que pertenece al género flavivirus y a la familia flaviviridae. Los principales vectores del virus son los mosquitos del género Culex, especialmente Culex tritaeniorhynchus. Los mosquitos vectores que transmiten la enfermedad prosperan con asiduidad en los arrozales asiáticos. Si acudimos a zonas endémicas es aconsejable emplear un repelente de insectos registrado, usar camisas de manga larga, pantalones largos y vacunarse.

El virus tiene una amplia gama de huéspedes vertebrados y parece que los cerdos y las aves zancudas actúan cómo huéspedes amplificadores. El virus se mantiene en circulación en un ciclo enzoótico de transmisión entre mosquitos, ganado porcino y/o aves lacustres. La transmisión de la enfermedad es más intensa durante la estación de lluvias, porque aumenta la población de vectores.
Los humanos y otras especies de mamíferos, como los caballos, sirven de anfitriones sin salida, ya que no se cree que la viremia alcance niveles que sean infecciosos para los mosquitos. Solo 1 de cada 25 a 1 de cada 1.000 infecciones en humanos produce síntomas. Sin embargo, la tasa de mortalidad de los casos sintomáticos es alta, alrededor del 20-30%, y alrededor del 30-50% de los sobrevivientes experimentan secuelas neurológicas y psiquiátricas significativas (paresia motora, espasticidad, trastornos del movimiento, convulsiones crónicas y retraso en el desarrollo).
Los casos de enfermedad grave están caracterizados por la repentina aparición de fiebre elevada, cefalea, rigidez de nuca, desorientación, coma, ataques, parálisis espástica y defunción.
No hay antivíricos, pero sí vacunas
No existe ningún tratamiento antivírico para pacientes con encefalitis japonesa, pero existen vacunas seguras y eficaces para prevenir la enfermedad. En la actualidad están disponibles cuatro tipos principales de vacunas contra la encefalitis japonesa: vacunas inactivadas derivadas del encéfalo de ratón, vacunas inactivadas derivadas de cultivos de células Vero, vacunas vivas atenuadas y vacunas vivas recombinantes.
La primera vacuna fue una vacuna de cerebro de ratón inactivada producida en Japón y fue utilizada en todo el mundo durante 50 años. Aunque la producción de vacunas de este tipo disminuyó en el año 2006, todavía se producen localmente vacunas similares de cerebro de ratón inactivado en Corea del Sur, Taiwán, Tailandia y Vietnam.
En los últimos años, en los países en los que la enfermedad es endémica, la vacuna viva atenuada SA14-14-2, fabricada en China, se ha vuelto las más ampliamente utilizada. En Europa solo está disponible la vacuna Ixiaro que contiene la cepa SA14-14-2 inactivada del virus de la encefalitis japonesa y es producida en células Vero y posteriormente purificada e inactivada.
Las estimaciones apuntan a que, entre los años 2000 y 2019, los programas de vacunación previnieron en todo el mundo 315 000 casos de encefalitis japonesa y 115.000 muertes por la enfermedad.
Desafortunadamente, el cambio climático global afecta a nuestro presente y futuro de forma muy diversa. Entre otras cosas porque ofrece una oportunidad para aumentar la distribución de la encefalitis japonesa a medida que se expanden los hábitats de los mosquitos vectores hacia áreas que antes no eran endémicas.
Por: Raúl Rivas González
Catedrático de Microbiología, Universidad de Salamanca